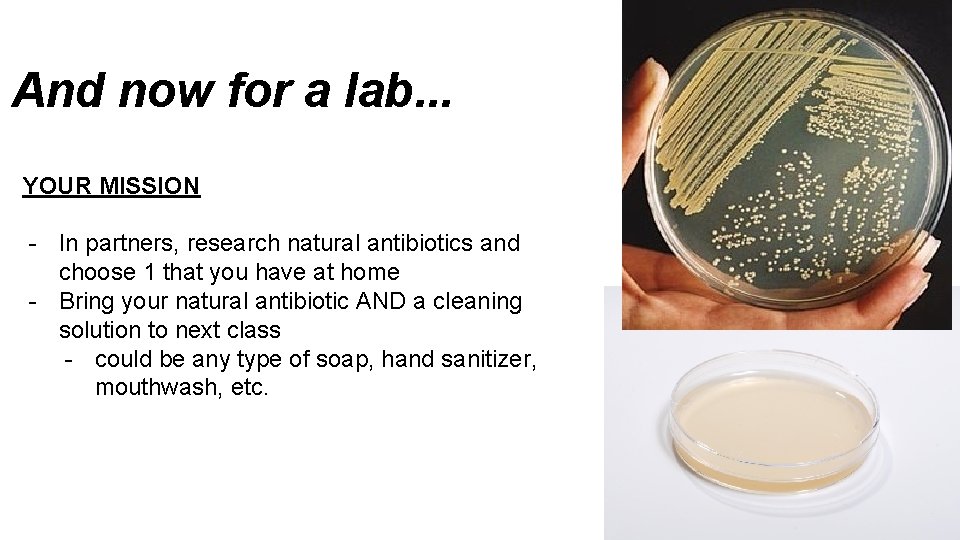
And now for a lab. . . YOUR MISSION - In partners, research natural And now for a lab. . . YOUR MISSION - In partners, research natural
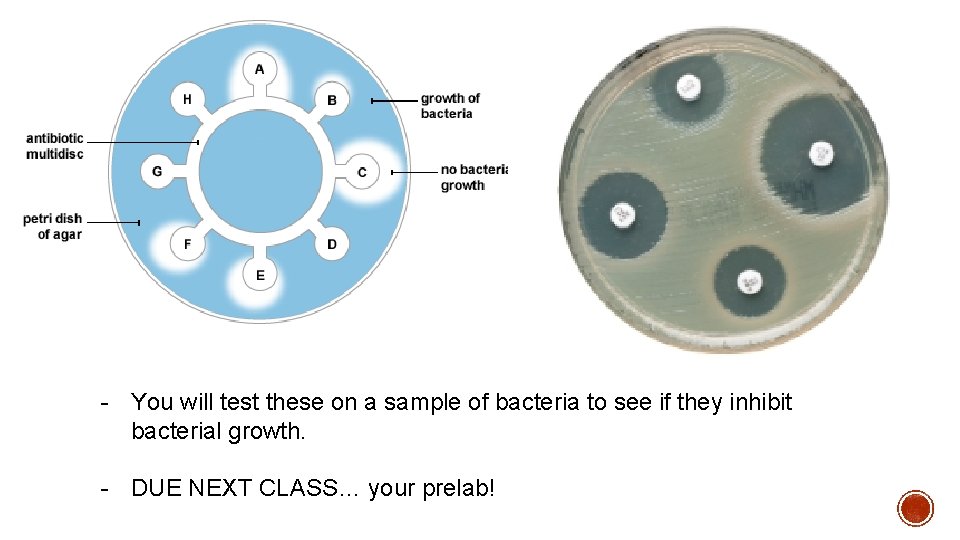
- You will test these on a sample of bacteria to see if they - You will test these on a sample of bacteria to see if they

1 5 Review What is the first line

- Slides: 31
1. 5 Review
What is the first line of defence for the Immune system? Skin, lining of organs
What part of the first line of defence helps trap pathogens? Mucus, phlegm, Hairs (hairlike structures)
What is in your stomach that kills pathogens? Strong acid
What is the key player in the Second Line of Defence for your Immune system? White Blood Cells
Why is inflammation our bodies natural response to an injury or infection? What does it help do? Affected area receives more blood to allow more white blood cells to arrive. Area’s temperature increases to help with antibiotic effects
What is the bodies Third Line of Defence? What does it help do? Specialized White Blood Cells = Antibodies Help fight the same pathogen in future attacks
What is the main difference between an Epidemic and Pandemic? An epidemic is a disease that spreads to many people rapidly in an area (one place). A pandemic is an epidemic that has spread over several countries or continents. Global scale outbreak
What is: Developed Immunity the ability of an organism to resist a particular infection or toxin by the action of specific antibodies or sensitized white blood cells. The body has been exposed to the pathogen before. Natural Immunity Immune to a disease without previous exposure to the pathogen (body already contains antigens)
1. 6 VACCINES AND ANTIBIOTICS
What is a vaccine? What benefits does it offer? Can you name some illnesses that you would get a vaccine for?
Vaccine: A substance that causes an immune response that prepares the immune system for future attacks WATCH THE FOLLOWING VIDEO: https: //www. youtube. com/watch? v=rb 7 TVW 77 ZCs
Four Different types of Vaccines: Live, Attenuated Vaccine • You are injected with live, but weakened microbes, that don’t cause the disease • Your immune system responds and remembers • Receive life-long immunity after 1 -2 shots Examples: Measles Mumps Chickenpox Yellow Fever
Inactivated Vaccines • You are injected with dead microbes • Your immune system responds somewhat and remembers • Receive immunity ONLY if booster shots are maintained Examples: Hepatitis A Rabies Whooping Cough
Subunit Vaccines • You are injected with Examples: specific pieces of microbes Hepatitis B • Your immune system Flu responds and remembers • Receive immunity after several doses
Toxoid Vaccines • You are injected with inactivated toxins from microbes that don’t cause disease • Your immune system responds and remembers • Receive immunity ONLY if booster shots are maintained Examples: Tetanus
WHAT LINE OF DEFENCE IS RESPONSIBLE FOR THE “REMEMBERING” IN VACCINES?
What do YOU think some benefits of vaccines are? With a partner brainstorm some benefits you think vaccines might offer. Why are these things good?
Benefits of vaccines Individual Immunity you avoid getting horribly sick all the time
Benefits of vaccines Individual Immunity you avoid getting horribly sick all the time Population Immunity If everyone is vaccinated, the disease can’t spread, even if a few aren’t vaccinated
Benefits of vaccines Individual Immunity you avoid getting horribly sick all the time Population Immunity If everyone is vaccinated, the disease cant spread, even if a few are vaccinated Disease eradication If everyone is vaccinated, the disease has no where to go, so it dies out (like smallpox – last case in 1977)
Benefits of vaccines Individual Immunity you avoid getting horribly sick all the time Population Immunity If everyone is vaccinated, the disease can’t spread, even if a few are vaccinated Disease eradication If everyone is vaccinated, the disease has no where to go, so it dies out (like smallpox – last case in 1977) Economic savings Billions of dollars saved in the health care system. Treating disease is expensive
Sometimes people choose not to vaccinate because severe reactions are possible: - High fever - Severe allergic reaction - Brain infection (meningitis)
These reactions are VERY RARE. These possible side effects for each vaccine are different Over the last decade, it has been scientifically proven countless times that vaccines do NOT cause two side effects that have been popularized on social media: Leukemia And Autism S E K YI
What are antibiotics? What benefits do they offer? Can you name some illnesses that you would take antibiotics for?
Antibiotics: - Chemical that affect bacteria - Kills bacteria (some dissolve cell membrane) - Prevent bacteria from growthing/reproducing - DOES NOT WORK ON VIRUSES
Many antibiotics were discovered from: - Plants - Fungi - Algae
Antibiotic Resistance & Superbugs - Watch the following video on antibiotic resistance. - What is antibiotic resistance? - How does it occur? - What is a superbug? https: //youtu. be/x. Zbcwi 7 Sf. ZE
And now for a lab. . . YOUR MISSION - In partners, research natural antibiotics and choose 1 that you have at home - Bring your natural antibiotic AND a cleaning solution to next class - could be any type of soap, hand sanitizer, mouthwash, etc.
- You will test these on a sample of bacteria to see if they inhibit bacterial growth. - DUE NEXT CLASS… your prelab!